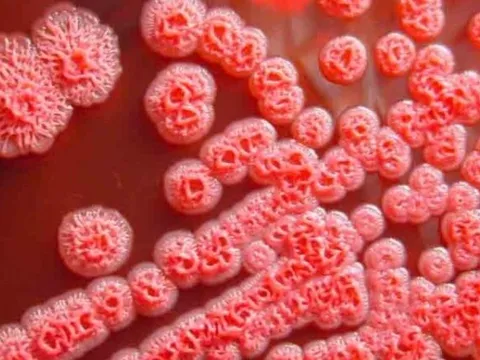
Những biểu hiện lâm sàng thường gặp của bệnh Whitmore

whitmore
Thanh Hóa: Bệnh nhi 15 tuổi mắc bệnh Whitmore đã tử vong
Sáng 19/9, ông Lê Đăng Khoa, Giám đốc Bệnh viện Nhi Thanh Hóa cho biết: bệnh nhi sinh năm 2008 mắc bệnh Whitmore hay còn gọi là ''Vi khuẩn ăn thịt người'' ở xã Tiên Trang, huyện Quảng Xương đã tử vong.
Đắk Nông: Ghi nhận trường hợp đầu tiên mắc Whitmore
Ngày 20/4, Sở Y tế Đắk Nông cho biết, địa phương vừa ghi nhận một trường hợp đầu tiên mắc Whitmore (do vi khuẩn Burkholderia pseudomallei gây ra, thường gọi là bệnh vi khuẩn ăn thịt người) tại xã Nam Dong (huyện Cư Jút).
Bệnh Whitmore ở trẻ - Những thông tin cha mẹ cần biết
Bệnh Whitmore có thể diễn biến nặng, tử vong, đặc biệt ở những người có bệnh nền như tiểu đường, bệnh gan, thận, phổi mạn tính, suy giảm miễn dịch.
Lý do nhiễm khuẩn Whitmore gây tử vong cao
Whitmore còn được mệnh danh là "kẻ bắt chước đại tài" vì triệu chứng gây ra khó nhận biết. Nhiều người được chẩn đoán khi đã muộn và không thể tránh khỏi cái chết.
Những biểu hiện lâm sàng thường gặp của bệnh Whitmore
Whitmore là bệnh nhiễm trùng ở người và động vật do vi khuẩn Burkholderia pseudomallei gây ra.
Bộ Y tế khuyến cáo 7 biện pháp phòng bệnh Whitmore
Bé trai 15 tuổi mắc bệnh Whitmore đã tử vong. Bộ Y tế khuyến cáo 7 biện pháp phòng bệnh.
Thanh Hoá: Bệnh nhi mắc "vi khuẩn ăn thịt người" đã tử vong
Bệnh viện Nhi trung ương thông tin bệnh nhi 15 tuổi (trú Thanh Hóa) mắc bệnh Whitmore (vi khuẩn "ăn thịt người") đã tử vong trong tình trạng suy đa tạng, hoại tử ruột.
Bộ Y tế chỉ đạo khẩn các biện pháp phòng bệnh Whitmore
Bộ Y tế khuyến cáo người dân chủ động phòng bệnh Whitmore, như: bảo đảm vệ sinh cá nhân, thường xuyên rửa tay với xà phòng và nước sạch, đặc biệt là trước và sau khi chế biến thức ăn, sau khi đi vệ sinh, sau khi đi làm ruộng, trước khi ăn. Thực hiện ăn chín, uống nước đun sôi để nguội, đảm bảo vệ sinh an toàn thực phẩm...
3 người bất ngờ phát hiện mắc bệnh Whitmore, có bé suy tạng phải thở máy
Một trong 2 bé trai ở Thanh Hoá phát hiện mắc khuẩn gây bệnh Whitmore sau khi dầm nước mưa, có diễn biến rất nặng, từng điều trị nhiều viện trước khi chuyển lên bệnh viện tuyến trung ương.
Đắk Lắk ghi nhận thêm 1 trường hợp mắc vi khuẩn ăn thịt người
Ngày 8/11, thông tin từ Bệnh viện Đa khoa vùng Tây Nguyên cho biết, trên địa bàn tỉnh vừa ghi nhận thêm 1 trường hợp mắc bệnh Whitmore tại huyện Krông Pắk.
Cảnh báo bệnh Whitmore tăng cao đột biến sau lũ
(NĐ&ĐS) - Ngày 17/11, theo bệnh viện Trung ương Huế, trong mùa bão lụt kéo dài tại các tỉnh Miền Trung từ đầu tháng 10 đến giữa tháng 11, lượt bệnh nhân mắc bệnh Whitmore nhập viện tại Bệnh viện tăng gần 30 ca trong chỉ hơn một tháng rưỡi.